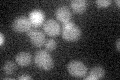

View description
Vacuolar aspartate and glutamate exporter; member of a family of seven genes (AVT1-7) related to vesicular GABA-glycine transporters; involved in compartmentalizing acidic amino acids in response to nitrogen starvation
Localization:
Intensity:
Fold change:
Significance:
-
C’ GFP library in SD
below threshold13.95 -
N' NOP1pr-GFP in SD

vacuole membrane87.6018 -
N' TEF2pr-mCherry in SD

vacuole membrane147.046 -
N' NATIVEpr-GFP in SD

vacuole22.3671 -
N' TEF2pr-VC and Cyto-VN in SD

below threshold28.5268 -
C’ GFP library in SD+DTT

cytosol15.681.12No -
C’ GFP library in SD+H2O2

cytosol13.440.96No -
C’ GFP library in Starvation Media

cytosol22.851.63No -
C’ GFP library on the background of Pup2-DaMP

below threshold -
C’ GFP library on the background of CCT mutant

below threshold14.41471.03245No
